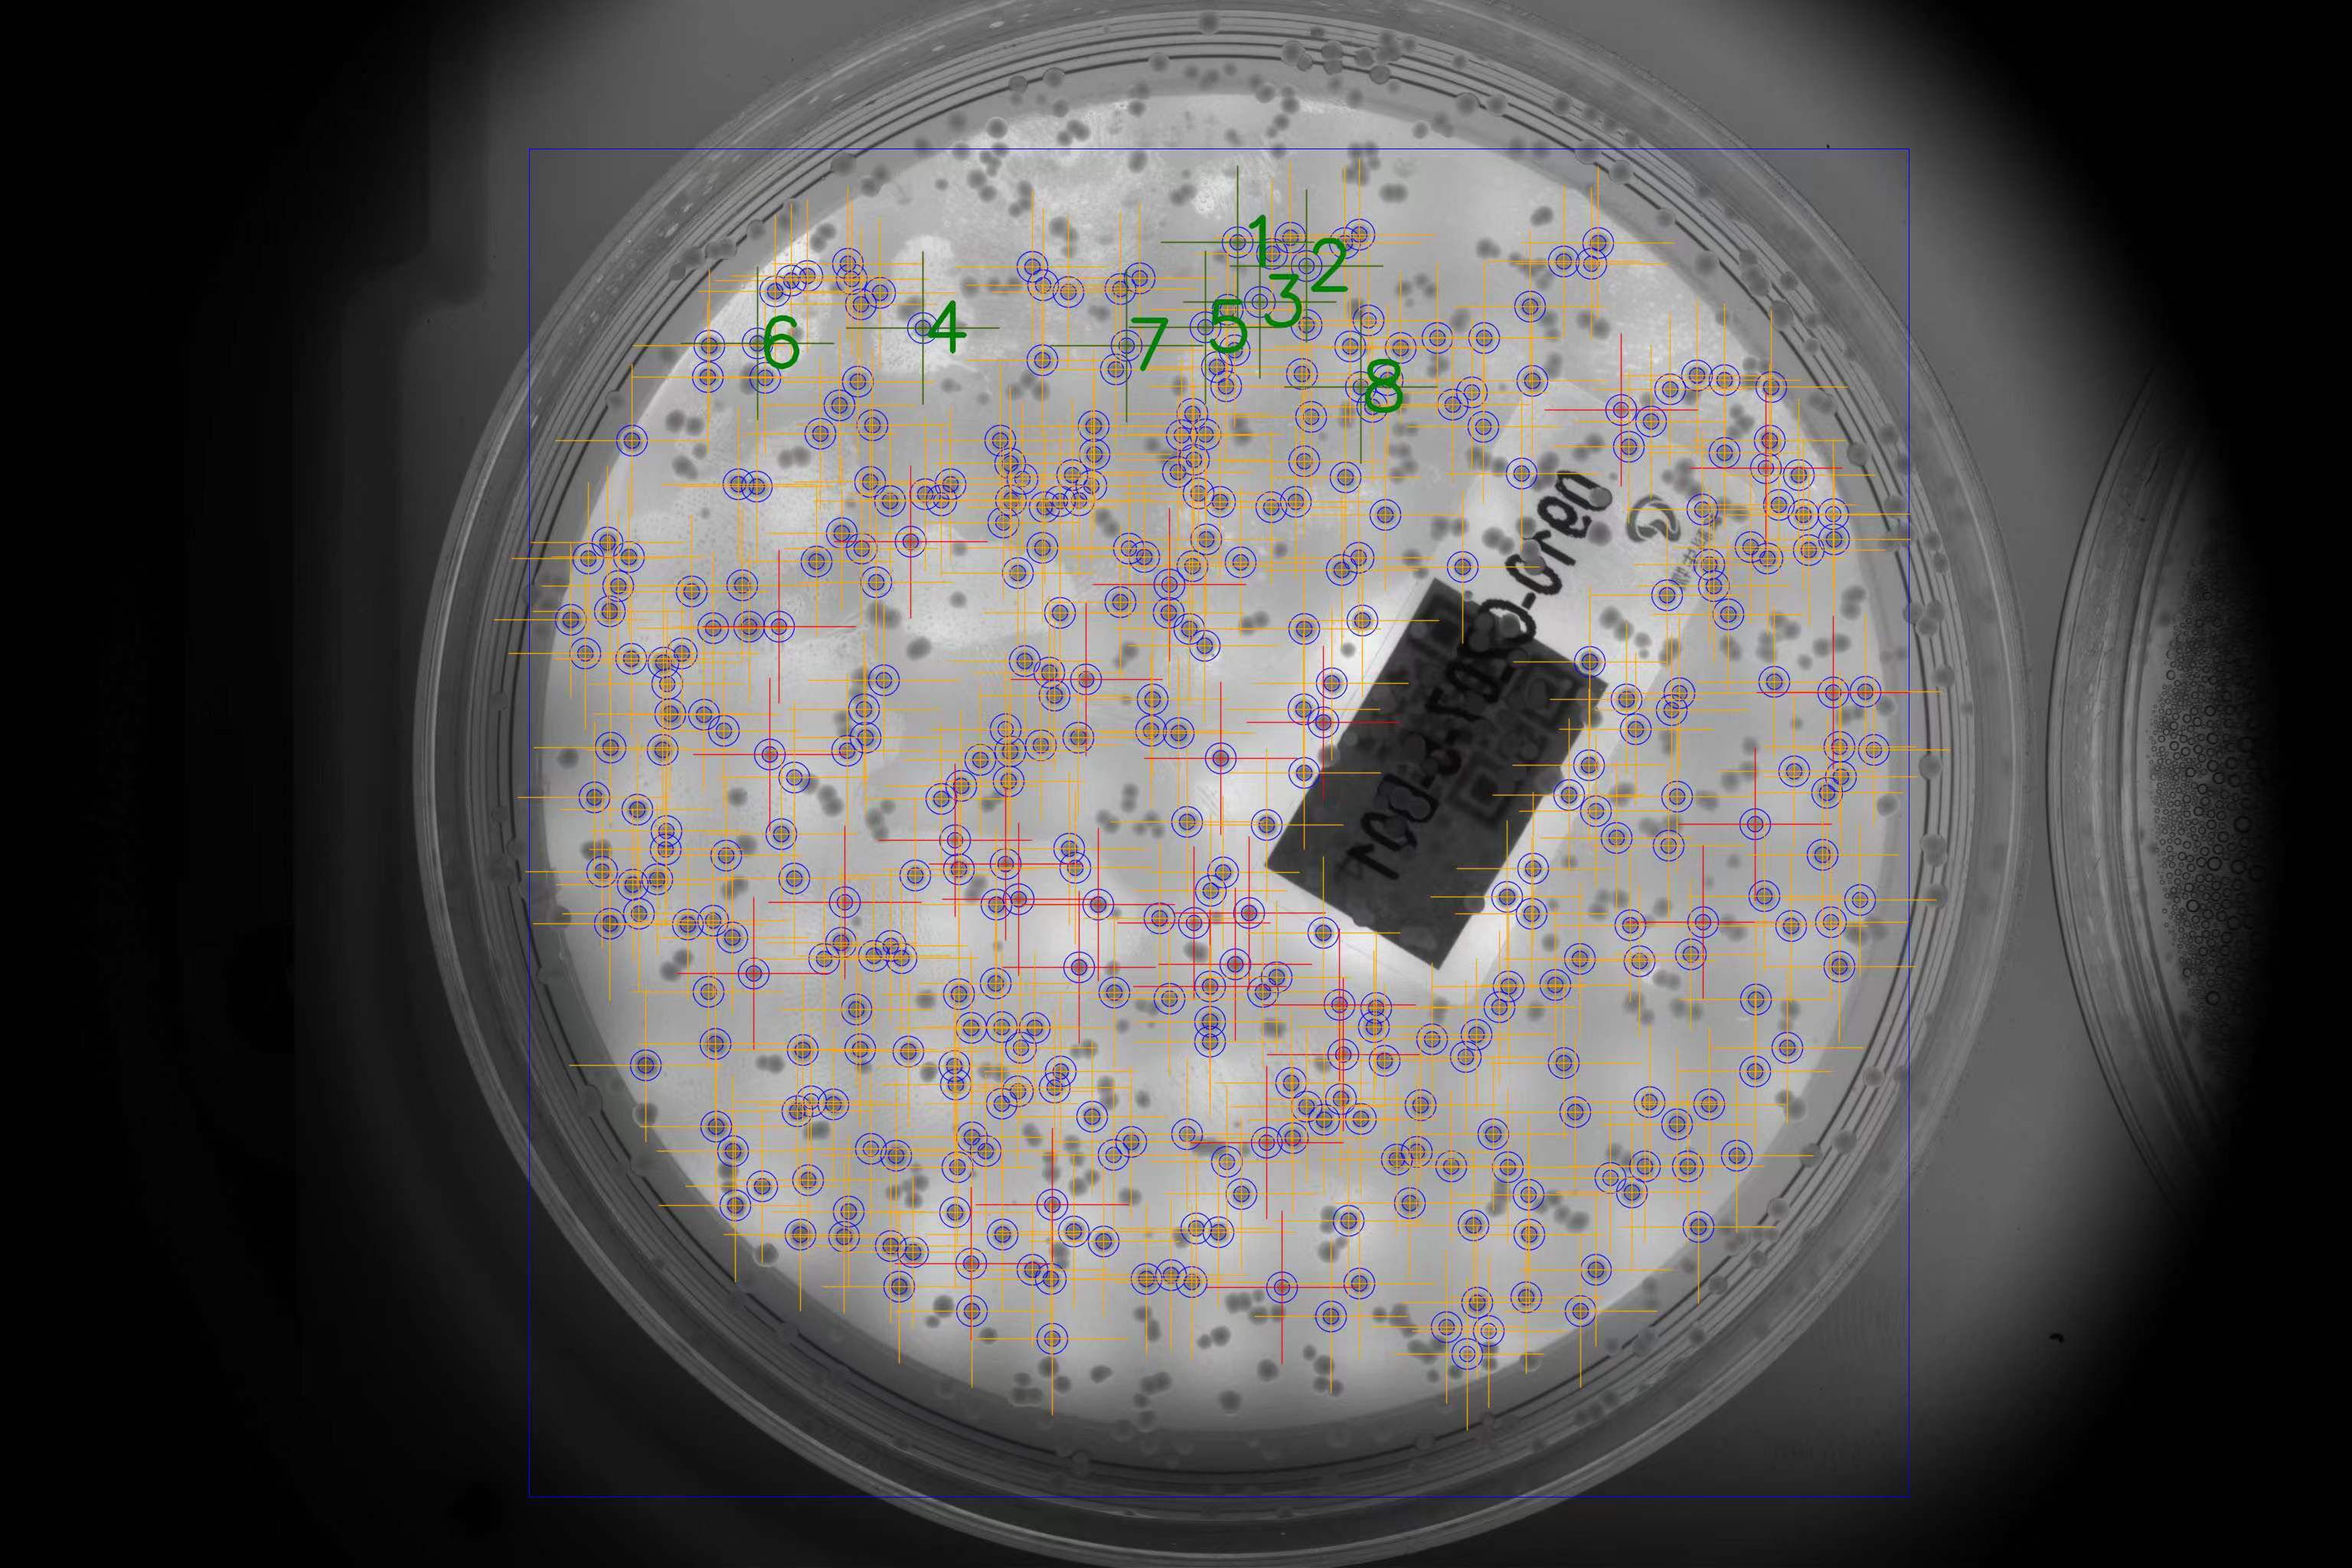
0d71b7fc5892e1d4999b6aae823c5ee 0d71b7fc5892e1d4999b6aae823c5ee

產(chǎn)品展示【部分】
聯(lián)系我們
- 青島市張彥欣單片機有限公司
- 山東.青島.城陽區(qū).博士后產(chǎn)業(yè)園
- [email protected]
- 266109
- 13864818820
- 張彥欣(項目開發(fā)20萬元起步)
最新資訊更多
- 青島工發(fā)柔性振動盤字符串通訊協(xié)議 2021-08-31
- 柔性振動盤 是精密自動化上料好幫手 2020-10-18
 鼠標(biāo)按住圖片可看放大效果
鼠標(biāo)按住圖片可看放大效果生物細(xì)菌采樣工作站 高通量 測序和基因合成 CRO 挑菌 微生物克隆篩選系統(tǒng)
-
查看次數(shù)5080
-
添加時間2023年08月04日
-
購買數(shù)量:
-
價格0.00元
源頭廠家,發(fā)明專利,自主研發(fā),可 隨意定制。
培養(yǎng)皿自動開蓋
自動識別細(xì)菌菌落(采集條件可設(shè)置)
自動采樣
保存過程數(shù)據(jù)
自動掃碼培養(yǎng)皿
自動掃碼96板
自動上盤(配上盤機)
自動下盤(配下盤機)
設(shè)計最高速度3500個/小時左右 (第二代升級產(chǎn)品最高5500/小時)
每一個客戶采樣過程都可能不一樣,免費定制程序

![]()